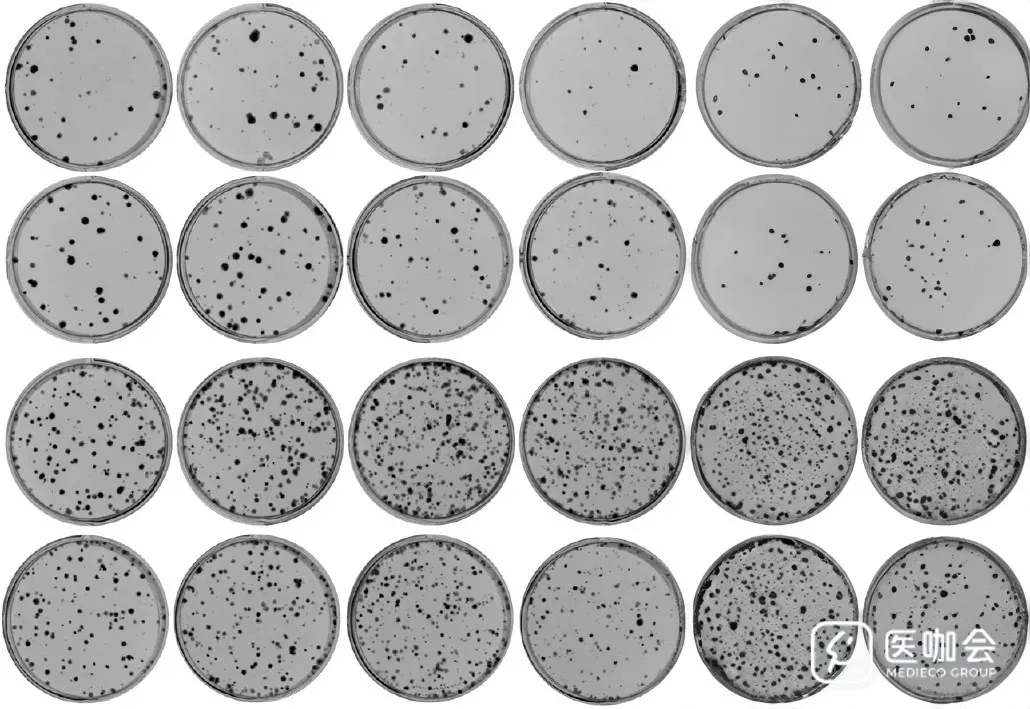
图片

学术侦探:AI深伪的实验结果图已能以假乱真
2024年8月27日,学术侦探Cheshire(柴郡猫)在社交媒体发布多篇推文,展示他使用生成式AI基于其他论文中的图片生成的五种实验结果图,分别是克隆形成实验(图2)、免疫荧光(图3)、免疫印迹(Western Blot,图4)、皮下荷瘤实验(图5)、和划痕实验(图6)。Cheshire称生成前四个结果只用了30秒,划痕实验的结果用了2分钟,并且尝试了很多次才得到较好的结果。他调侃道:
“No lab required - think of all the money we'll save!😼”(无需实验室——想想我们将节省多少钱!)
图1 Cheshire的推文
图2 右侧两列由AI生成
图3 最右侧的图由AI生成,左侧的四张图来自2023年发表在Journal of Translational Medicine的论文。
图4 最右侧的条带由AI生成
图5 最右侧一列由AI生成
图6 第一和第四行由AI生成
五张图片由AI生成的部分十分逼真。特别是图5,Cheshire称镜头光晕和阴影尤为以假乱真。Cheshire未披露他使用的AI与提示词,他在与网友的交流中提到,他没有办法分辨这些图像的真假,他知道这些图像由AI生成的唯一原因是他生成了它们(I only know because I made them.)。还提到图像检测软件ImageTwin也无法发现AI生成的右侧两列的问题(图7)。
图7 Cheshire展示ImageTwin未检测到AI生成的右侧两列与任何出版物中的图片重复
Cheshire称目前没有可以有效检测图像是否由AI生成、或者是否包含由AI生成的内容的软件,这让他对论文工厂使用AI造假感到担忧。尽管我们难以识别AI深伪的实验结果,但他依然相信,公开原始数据有助于证明实验的真实性。这种观点可能基于这样的事实:AI目前还无法生成具有完全相同关键特征和信息的不同图片,例如使用不同摄影器材拍摄,或者特定实验步骤前后的照片。
------分割线------
点击链接:会员-医咖社区 (mediecogroup.com),成为医咖会员,学习SPSS、预测模型等50门科研课程!